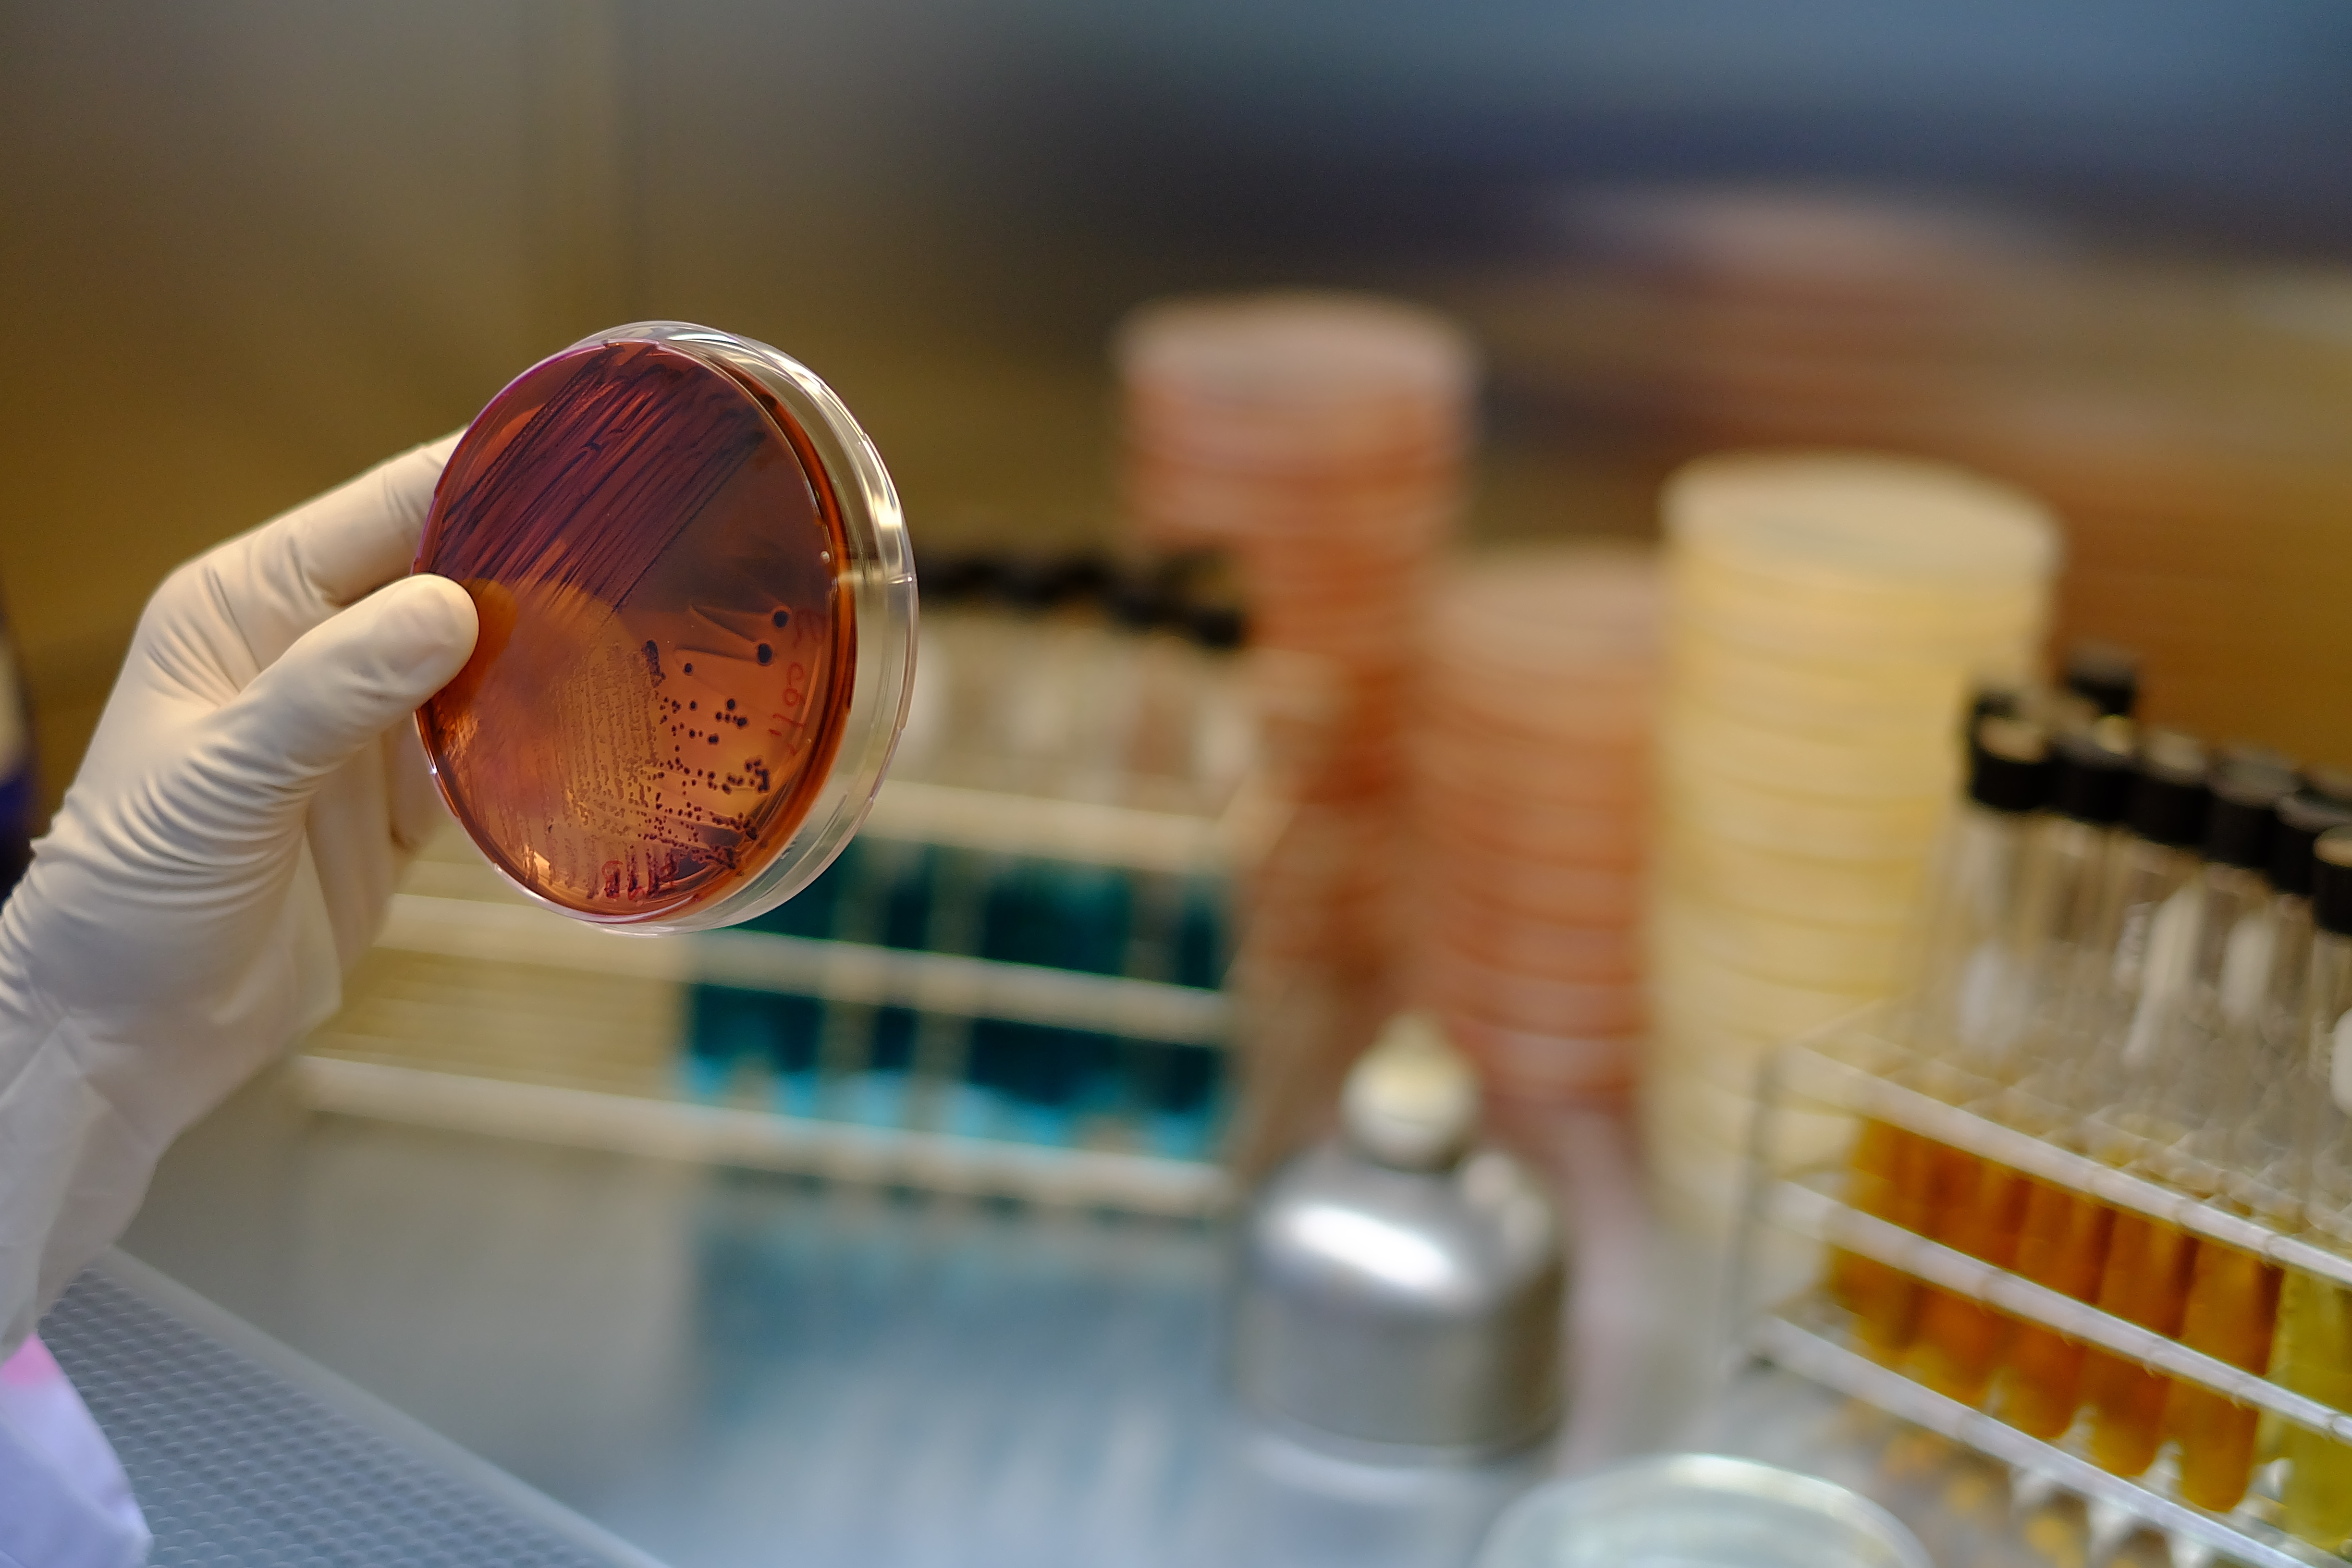

Hieronder vallen alle eencelligen zoals bacteriën, protozoa (waaronder de amoeben), eencellige algen en schimmels (waaronder de gisten). Virussen en prionen worden niet tot de micro-organismen gerekend (maar wel tot microbiologie), omdat ze niet als levend worden gezien.
Aansluitend profiel
- Natuur en Techniek
- Natuur en Gezondheid
Meest relevante vakken
- Natuurkunde
- Natuur, leven en technologie
- Scheikunde
- Wiskunde B
Voorbeelden van vragen
Micro-organisme- Kunnen micro-organismen nuttig zijn?
- Hoeveel micro-organismen zitten er in filet americain?
- Wat is de werking van antibiotica op micro-organismen?